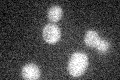
YGL250W
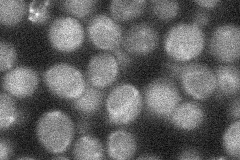
YGL250W

View description
Protein required for meiotic recombination and gene conversion; null mutant displays reduced PIS1 expression and growth defects on non-fermentable carbon sources and minimal media; GFP-fusion protein localizes to both cytoplasm and nucleus
Localization:
Intensity:
Fold change:
Significance:
-
C’ GFP library in SD
below threshold17.23 -
N' NOP1pr-GFP in SD

below threshold20.5792 -
N' TEF2pr-mCherry in SD

missing0 -
N' NATIVEpr-GFP in SD
below threshold20.8319 -
N' TEF2pr-VC and Cyto-VN in SD

#N/A0 -
C’ GFP library in SD+DTT

cytosol18.081.04No -
C’ GFP library in SD+H2O2

cytosol13.230.76No -
C’ GFP library in Starvation Media

cytosol14.470.83No -
C’ GFP library on the background of Pup2-DaMP

below threshold -
C’ GFP library on the background of CCT mutant

below threshold17.2050.99802No
